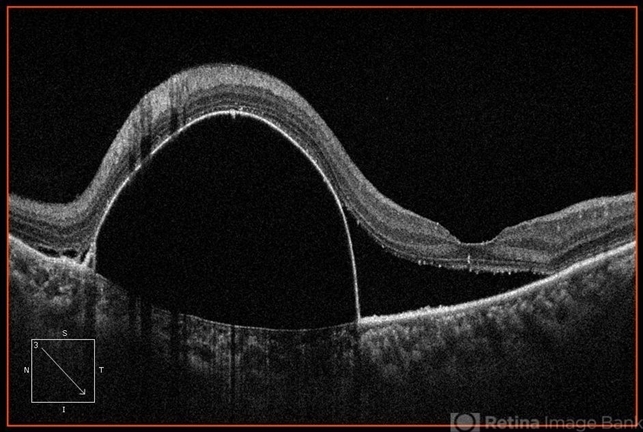

File number: 26808
Comments
-
JEFFERSON R SOUSA, Tecg.º (Biomedical Systems Technology) (November 26 2016)
Dear Mr. Said, first of all thanks for the comment. Is likely to be a Crcs, in accordance with the patient's history has led the medical team to suggest as a first chance diagnoses.. However, questioned a possible Polipoide in which we're investigating at the moment.
Thanks
Jefferson -
Image Bank Member (November 26 2016)
cscr
Sign in to comment.
-
By JEFFERSON R SOUSA, Tecg.º (Biomedical Systems Technology)
Institute Suel Abujamra
Co-author(s): Dr. André M. V. Gomes, Study Center and Ophthalmological Research - São Paulo-Brazil - Uploaded on Nov 20, 2016.
- Last modified by Caroline Bozell on Nov 21, 2016.
- Rating
- Appears in
- Miscellaneous
- Condition/keywords
- pigment epithelial detachment (PED), large pigment epithelial detachment
- Photographer
- JEFFERSON R SOUSA - Study Center and Ophthalmological Research Dr. Andre M V Gomes, Institute Dr. Suel Abujamra São Paulo-Brazil
- Imaging device
-
Optical coherence tomography system
OCT Cirrus - Zeiss / Cut in line from 11 to 5hr. - Description
- Female patient, 43-years-old, Caucasian. Attended the clinic with complaint of low vision. In the fundus evaluation, DEP was observed in the upper region with macular involvement.